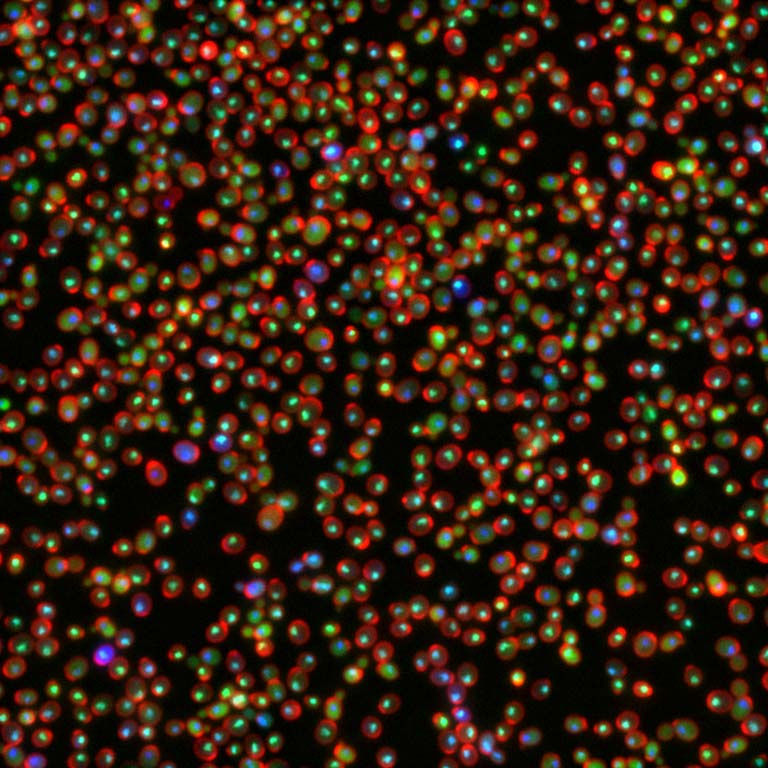

Yeast Cells Respond to Alkylation Damage
Yeast Cells Respond to Alkylation Damage
Collections: Cancer Discovery Science
Aprotim Mazumder, Laia Quiros Pesudo, Siobhan McRee, Mark Bathe and Leona D. Samson
Koch Institute at MIT, MIT Center for Environmental Health Sciences, MIT Department of Biological Engineering
"Many, even most, cancers are associated with impaired DNA repair capacity in cells. A holistic response to DNA damage involves modulation of not just the canonical DNA repair pathways, but of myriad different cellular processes. Budding yeast while unicellular, is an ideal model organism for studying such responses. This image was taken as a part of a genome-wide screen to assess global reorganization of the yeast proteome in terms of levels and localization, in response to alkylation damage. Here a critical protein called Rnr4 marked with a Green Fluorescent Protein (GFP) tag, is shown in green. The cell-wall is marked in red and DNA in blue. Such high throughput images across thousands of different GFP strains, allows us to monitor changes in both protein levels and localization in response to DNA damage."